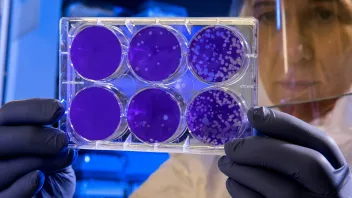

News
Cordlife appoints independent financial advisor for partial offer
Cordlife appoints independent financial advisor for partial offer
The offer is for 10.68% shares in the company.
Singapore, IEA collaborate on capacity building to support regional grid targets
The programme focused on educating stakeholders about multilateral power trade.
NIE NTU, AWS sign three-year deal to advance EdTech
A key initiative under this MoU is the launch of the Technology for Education Centre.
MAS’ advisory committee to review governance code
The review aims to enhance the transparency and market appeal of listed companies.
Keppel appoints Piyush Gupta as Deputy Board Chairman
Keppel’s board now has seven independent directors.
MAS appoints Goh Swee Chen and Ho Teck Hua as board members
MAS said both have been appointed for a three-year term ending 31 May 2028.
Minister Fu urges ASEAN unity on climate amidst extreme weather
She stressed the worsening impact of climate change, citing recent extreme weather across Southeast Asia.
M1 launches 5G RedCap service with enterprise IoT in focus
The technology is intended to bridge the gap between older IoT standards and full 5G, according to M1.
Singapore flags context-based GenAI risks in global pilot
One of the key findings is that GenAI risks, such as hallucinations, content safety, and data leakage, are highly context-dependent.
Rental demand climbs with smaller units in focus
The growth was led entirely by the non-landed segment, which saw a 5.2% QoQ increase.
S’poreans stick with traditional channels for brand access
They prefer email and phone calls when connecting with brands.
Daily Markets Briefing: STI down 0.18%; Top stock is SGX
SGX is the top stock with a 2.29% increase.
Majority of 2024 corruption cases come from private sector
Only 9% are public sector cases.
Amara Holdings takeover offer ‘fair and reasonable’—IFA
The offer was for $0.895 cents per share.
Half of businesses passing off tariff hikes to manage costs
8 in 10 are cautious about expanding and investing.
TOTM Technologies CEO, directors resign after EGM bid
Their resignation followed requisition notices from nine shareholders.
New MERaLiON update boosts multilingual processing, emotional intelligence
The model now also supports Malay, Tamil, Thai, Indonesian, and Vietnamese languages.

Advertise
Advertise















Commentary
Singapore’s AI upskilling push is bold. Now employers must close the loop.
Why Budget 2026 marks a turning point for employers
Budget 2026: Cushioning carbon tax burden and maintaining competitiveness
Beyond fuel choice: Budget 2026 and Singapore’s structural strategy in low-carbon transport
Why phishing and software updates still matter for Singapore organisations
Why Singapore businesses must focus on outvaluing, not just upskilling